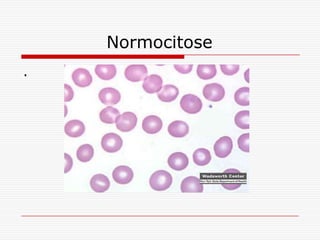
Normocitose
.
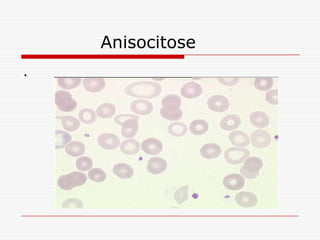
Anisocitose
.
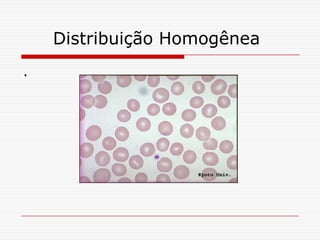
Distribuição Homogênea
.
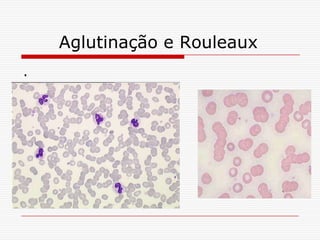
Aglutinação e Rouleaux
.
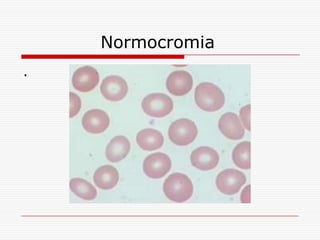
Normocromia
.
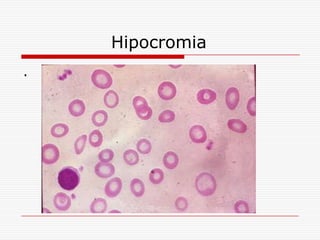
Hipocromia
.
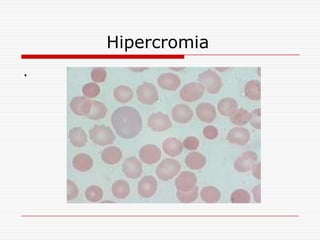
Hipercromia
.
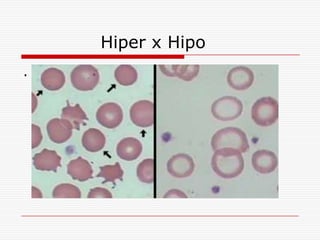
Hiper x Hipo
.
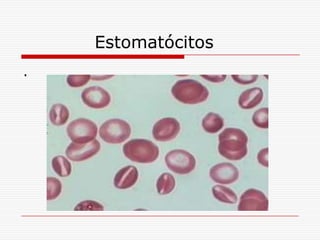
Estomatócitos
.
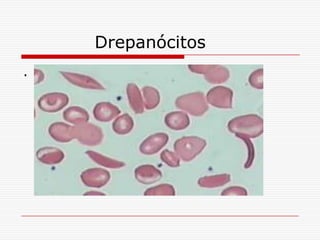
Drepanócitos
.
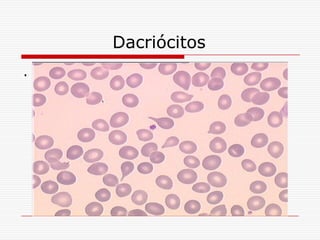
Dacriócitos
.
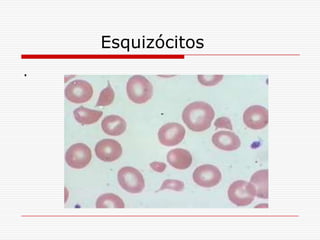
Esquizócitos
.
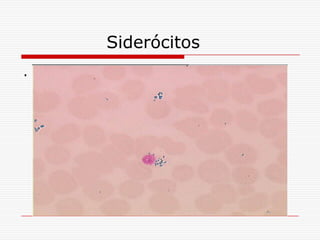
Siderócitos
.
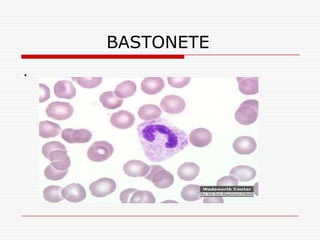
BASTONETE
.
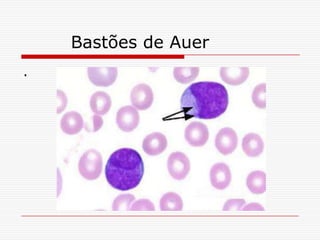
Bastões de Auer
.
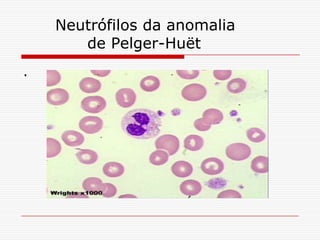
Neutrófilos da anomalia
       de Pelger-Huët
.
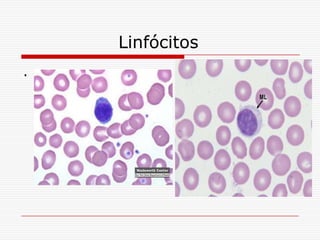
Linfócitos
.
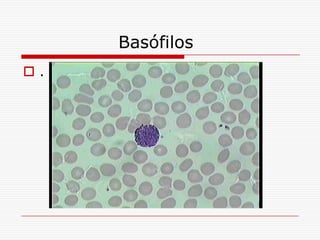
Basófilos
.
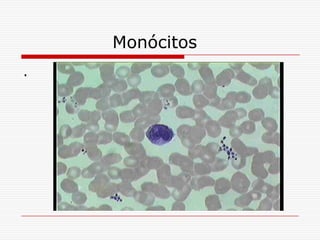
Monócitos
.

O documento apresenta um resumo do hemograma, que avalia os elementos celulares do sangue de forma quantitativa e qualitativa. O hemograma é composto pelo eritrograma, leucograma e plaquetograma. O eritrograma avalia a massa eritróide circulante quantitativa e qualitativamente.